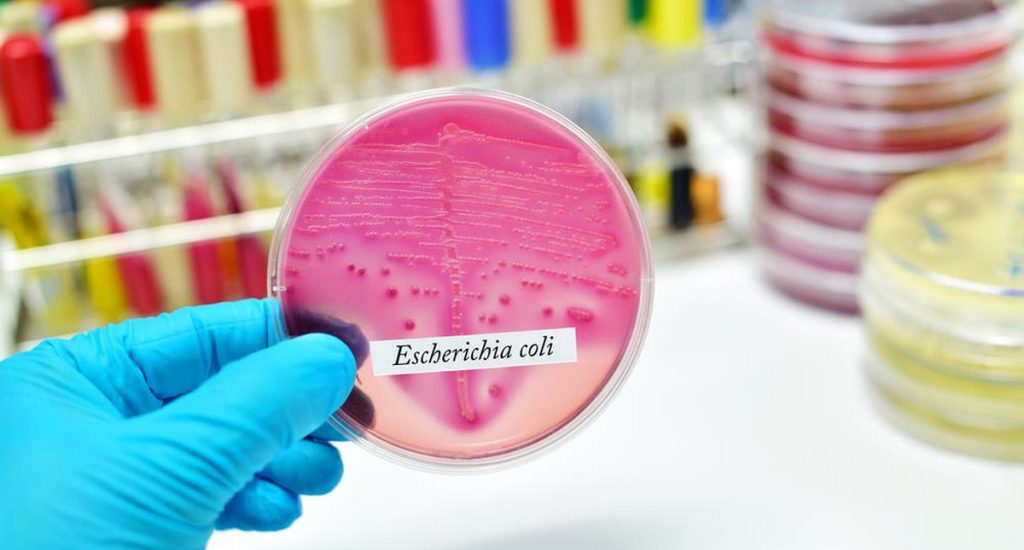

Vai trò của nước trong chăn nuôi
Trong ngành chăn nuôi hiện đại, ngoài thức ăn, con giống và chuồng trại thì nước uống và nước sử dụng trong trang trại chính là một yếu tố sống còn ảnh hưởng trực tiếp đến sức khỏe và năng suất của đàn vật nuôi. Tuy nhiên, yếu tố này lại thường bị xem nhẹ hoặc không được kiểm soát chặt chẽ, đặc biệt tại các trang trại quy mô nhỏ và vừa.

Nước có vai trò quan trọng trong ngành chăn nuôi
Theo nhiều nghiên cứu có hơn 70% các bệnh tiêu chảy và viêm ruột ở vật nuôi có liên quan đến nguồn nước không đảm bảo vệ sinh, đặc biệt là nhiễm khuẩn E.colivà các loại coliform. Vi khuẩn này tồn tại phổ biến trong đất, nước và có thể dễ dàng lây lan qua máng uống, máng ăn hoặc hệ thống nước dùng chung cho toàn trại.
Chính vì vậy, việc kiểm tra và giám sát chất lượng nước định kỳ, đặc biệt là phát hiện sớm sự hiện diện của vi khuẩn E. coli, là một bước quan trọng trong công tác phòng bệnh chủ động và giảm thiểu thiệt hại kinh tế cho người chăn nuôi.
Vi khuẩn E. coli trong chăn nuôi
Vi khuẩn Escherichia coli (E. coli) là một trong những loại vi khuẩn phổ biến nhất trong hệ vi sinh đường ruột của động vật. Tuy nhiên, một số dòng E. coli có độc lực cao có thể gây ra:
• Tiêu chảy cấp và mãn tính;
• Viêm ruột;
• Suy giảm miễn dịch;
• Chậm tăng trọng;
• Tăng tỷ lệ chết trong giai đoạn nhạy cảm.
Trong môi trường trại, E. coli dễ dàng phát tán qua:
• Nước uống không xử lý;
• Hệ thống nước tái sử dụng;
• Máng ăn, máng uống bị nhiễm bẩn;
• Vật dụng vệ sinh không khử trùng;
• Nước thải, nước rửa chuồng trại.
Khi vật nuôi nhiễm E. coli, người chăn nuôi thường phải dùng kháng sinh để điều trị, làm gia tăng chi phí và nguy cơ kháng kháng sinh, một vấn đề đang rất đáng lo ngại trong ngành thú y hiện nay.
AquaCHROM ECC là gì?

Sản phẩm Aqua CHRO Magar
AquaCHROM ECC là một loại môi trường nuôi cấy vi sinh chuyên dụng, được thiết kế đặc biệt để kiểm tra nhanh sự hiện diện của vi khuẩn E. coli và coliforms trong nước. Sản phẩm được phát triển bởi CHROMagar (Pháp), hãng tiên phong trong lĩnh vực môi trường nuôi cấy chomogenic (đổi màu).
Khác với các phương pháp truyền thống yêu cầu nhiều bước và thiết bị, AquaCHROM ECC sử dụng cơ chế phản ứng enzyme đặc hiệu, cho phép:
• Phân biệt E. coli và coliforms khác dựa vào màu sắc.
• Không cần thêm hoá chất nhuộm hay bước thử sinh hoá.
• Cho kết quả chỉ sau 18- 24 giờ ủ mẫu.
Màu sắc nhận diện:
| Vi khuẩn | Màu môi trường |
| E.coli | Xanh lá |
| Coliforms khác | Xanh đậm |
| Vi khuẩn khác | Chuyển màu vàng nhạt |
Chỉ cần một bước ủ đơn giản, người chăn nuôi tại trại hoặc kỹ thuật viên thú y có thể thực hiện xét nghiệm tại chỗ, đọc kết quả trực tiếp bằng mắt thường, không cần thiết bị phân tích phức tạp.

Ứng dụng thực tế của AquaCHROM ECC trong chăn nuôi
Kiểm tra chất lượng nước uống
Đây là ứng dụng phổ biến và quan trọng nhất. Nước giếng khoan, nước ao, nước máy chưa qua xử lý triệt để có thể tiềm ẩn nguy cơ ô nhiễm vi sinh vật. Việc kiểm tra định kỳ giúp:
• Đảm bảo nước cung cấp cho đàn vật nuôi kịp thời và an toàn.
• Quyết định thời điểm cần thay nguồn nước hoặc xử lý bằng clo, ozon, UV,…
• Ngăn ngừa bùng phát dịch tiêu chảy, viêm ruột.
• Tăng năng suất.
Giám sát kiềm tra nước vệ sinh chuồng trại
Hệ thống vệ sinh chuồng bằng nước nếu không được quản lý tốt sẽ trở thành nguồn lan truyền mầm bệnh. AquaCHROMagar ECC có thể áp dụng để:
• Kiểm tra nước rửa chuồng, máng ăn, hệ thống xịt rửa.
• Đánh giá hiệu quả của quy trình vệ sinh và khử trùng.
Hỗ trợ truy vết khi có dịch bùng phát
Khi xảy ra tiêu chảy hàng loạt, việc truy tìm nguồn lây là vô cùng quan trọng. Sản phẩm có thể kiểm tra mẫu nước từ nhiều vị trí trong trại, giúp xác định nhanh nguồn ô nhiễm, đưa ra phương án xử lý kịp thời.
Tăng năng suất và tiết kiệm chi phí
• Giảm tỷ lệ vật nuôi mắc bệnh.
• Giảm chi phí thuốc kháng sinh.
• Giảm hao hụt do chết.
• Tăng tốc độ tăng trưởng và năng suất đầu ra.
Giải pháp mở rộng và hỗ trợ kỹ thuật
CHROMagar và các đối tác tại Việt Nam hiện đã xây dựng quy trình chuẩn sử dụng AquaCHROM ECC tại trang trại, bao gồm:
• Tài liệu hướng dẫn sử dụng chi tiết, ngắn gọn, dễ hiểu.
• Video minh họa thao tác.
• Hỗ trợ đánh giá kết quả qua hình ảnh.
• Tư vấn kỹ thuật miễn phí, tận nơi cho trại chăn nuôi và phòng lab thú y.
Phòng bệnh từ gốc – Bảo vệ đàn vật nuôi từ nguồn nước
AquaCHROM ECC không chỉ là một sản phẩm kiểm nghiệm vi sinh mà là một giải pháp chiến lược giúp người chăn nuôi phòng bệnh chủ động, tăng hiệu quả kinh tế và giảm thiểu rủi ro dịch bệnh.
Với thao tác đơn giản, chi phí hợp lý và kết quả nhanh chóng, sản phẩm đang dần trở thành lựa chọn phổ biến trong các trại chăn nuôi chuyên nghiệp, trung tâm giống, và phòng xét nghiêm thú y trên cả nước.
CÔNG TY TNHH KHOA HỌC KỸ THUẬT TOÀN CẦU
Công ty TNHH Khoa học Kỹ thuật Toàn Cầu được thành lập vào tháng 11 năm 2006, là công ty hàng đầu tại Việt Nam cung cấp các sản phẩm thiết bị sinh học, công nghệ sinh học và hóa chất. Toàn Cầu với sứ mệnh mang những tiến bộ kỹ thuật của thế giới phục vụ phát triển khoa học công nghệ của Việt Nam.
Ông Mr. Đinh giới thiệu về những dịch vụ chẩn đoán trong lĩnh vực chăn nuồi của Công ty.
Địa chỉ liên hệ:
Trụ sở: Lầu 19, khu A, số 4 Nguyễn Đình Chiểu, Phường Đa Kao, Quận 1, TP. Hồ Chí Minh, Việt Nam.
Văn phòng TP. Hồ Chí Minh: 48 Châu Thị Hóa, Phường 4, Quận 8, TP. Hồ Chí Minh.
Văn phòng TP. Hà Nội: Số nhà 59B, ngõ 148 Trần Duy Hưng, Phường Trung Hòa, Quận Cầu Giấy, TP. Hà Nội
Email: dinh@global.net.vn
Hotline: 0908 090 555 (Mr Đinh)
Website: www.global.net.vn